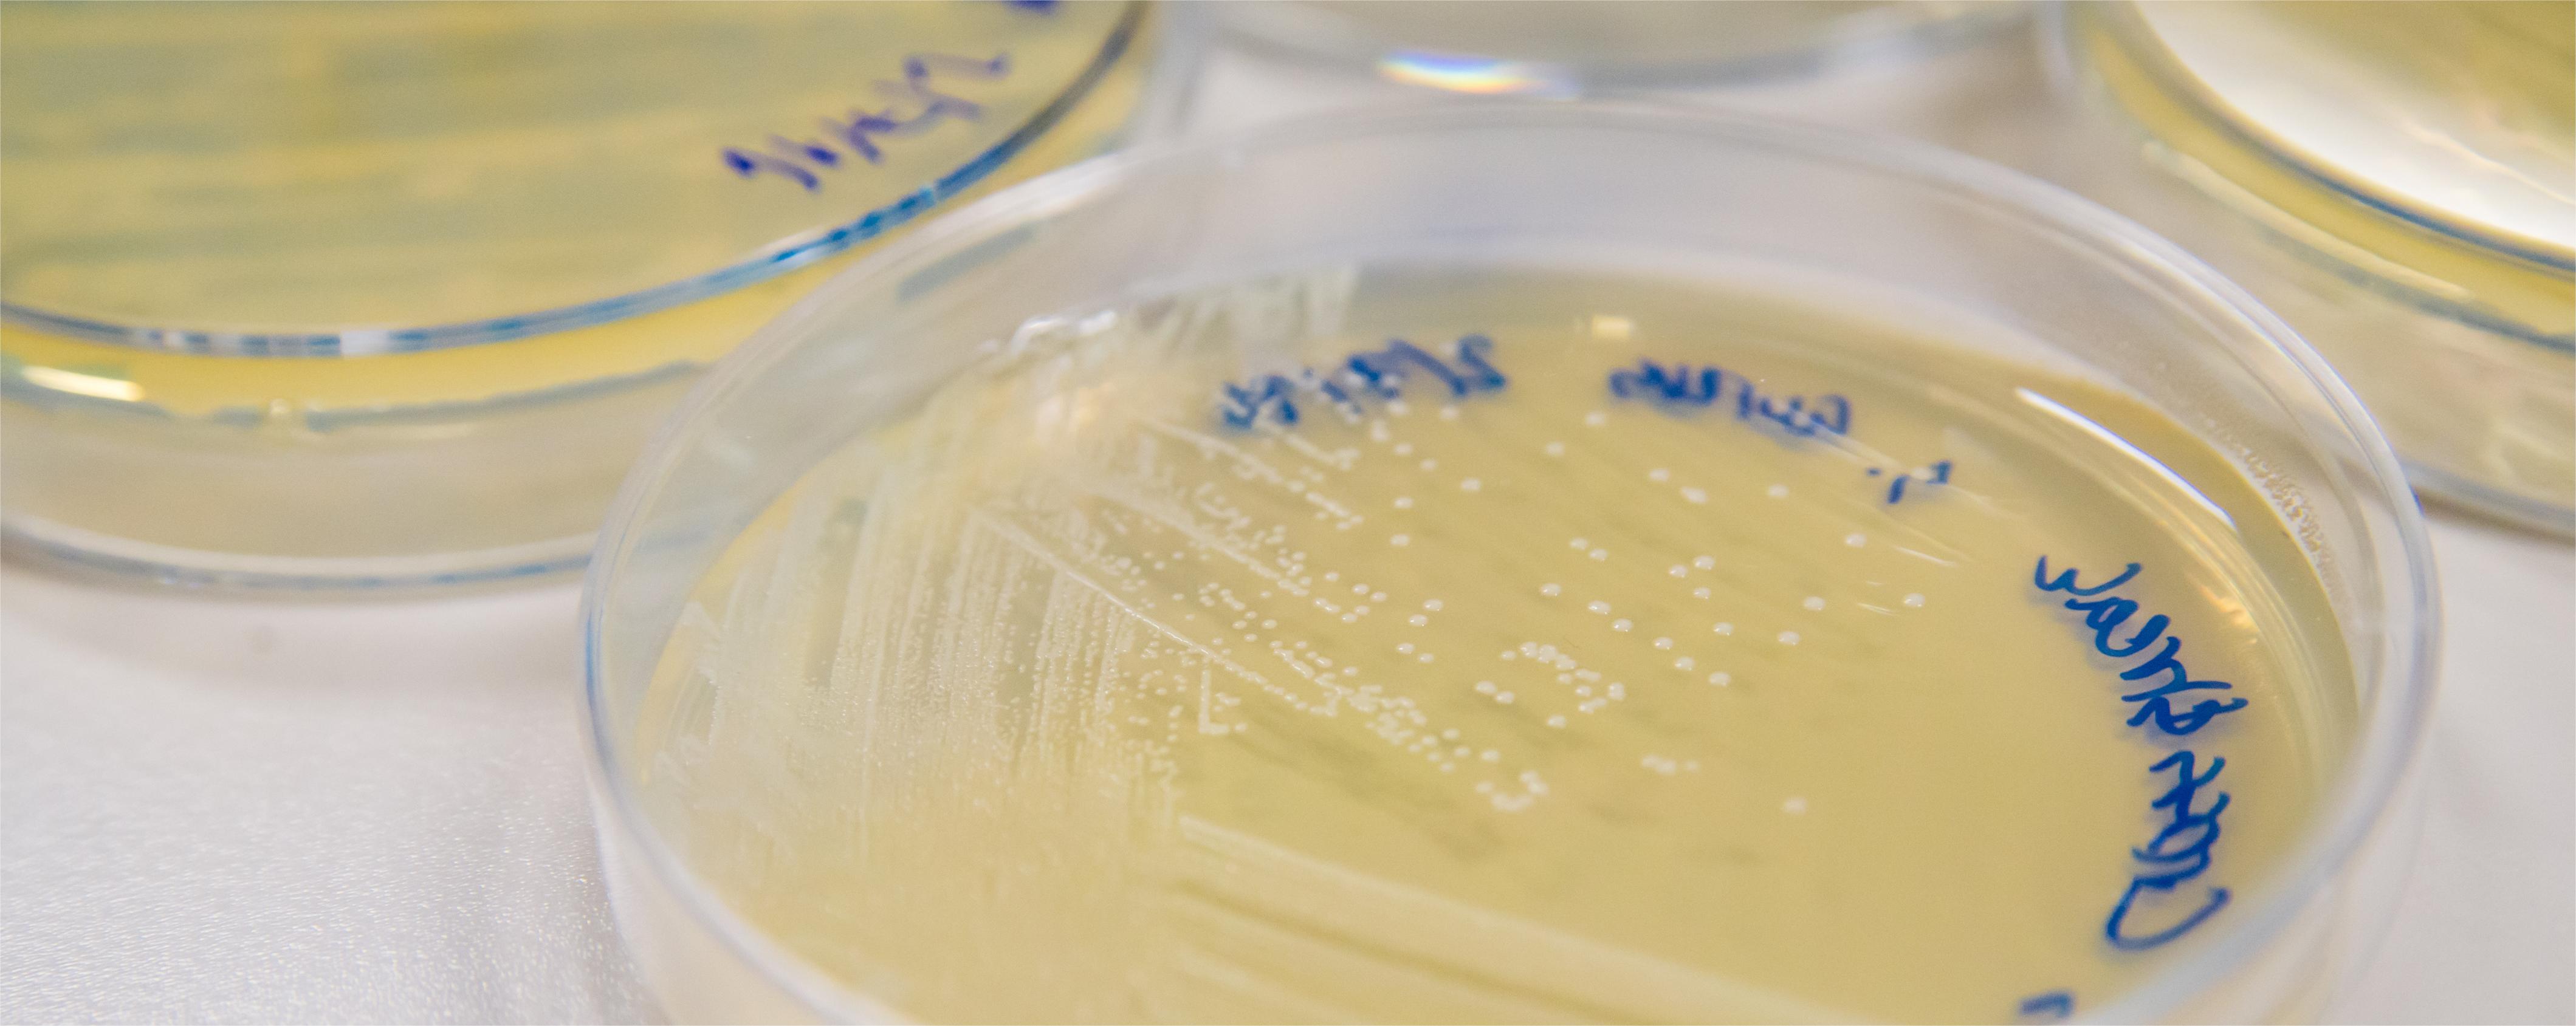
原核大肠杆菌表达服务

The study of proteins or their applications in biotechnological contexts often requires their individual isolation. Methods for purifying proteins from natural sources are typically cumbersome and inefficient for most individuals. Escherichia coli, due to its rapid growth, ease of handling, and cost-effectiveness, has become the preferred host for recombinant protein production. Today, many commercially valuable proteins are produced in Escherichia coli, simultaneously, in the laboratory, E. coli recombinant expression of proteins is the preferred method for studying their structure and function.
Our E. coli expression platform has gathered various N and C-terminal tags, as well as a variety of expression vectors tailored for different host strains, ensuring the selection of the most effective system and expression scheme.